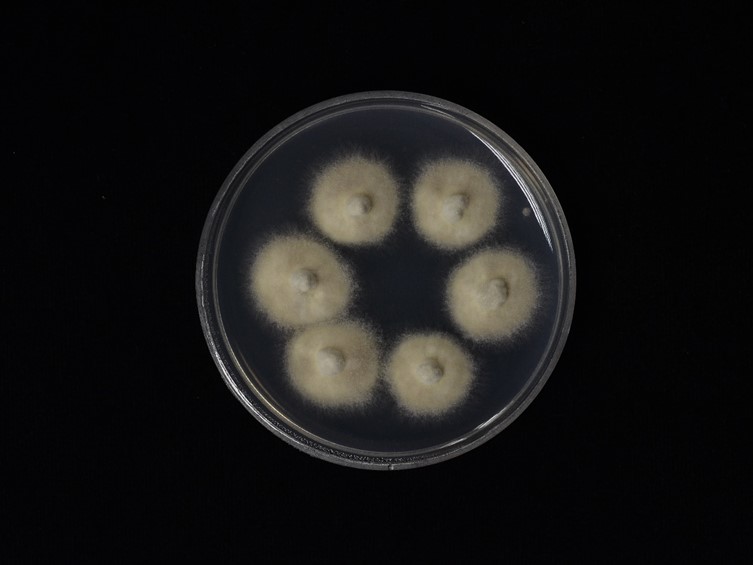

Holotype:
THAILAND, Kalasin Province, Khok Pa Si Community Forest, 14 Jun. 2011, K. Tasanathai, P. Srikitikulchai, A. Khonsanit, K. Sansatchanon, W. Noisripoom, holotype BBH 32173, ex-type living culture BCC 48071.
Habitat:
Buried in the soil.
Host:
Termite.
Description:
 Stroma solitary, simple, cylindrical, 16 cm long, 1 mm wide, brown ca 5.5 cm emerging above the leaf litter, ca 10.5 cm buried in the soil. Asexual morph (Hirsutella) produced ca 1.5 cm at the terminal part of the stroma, light brown to grey.
Stroma solitary, simple, cylindrical, 16 cm long, 1 mm wide, brown ca 5.5 cm emerging above the leaf litter, ca 10.5 cm buried in the soil. Asexual morph (Hirsutella) produced ca 1.5 cm at the terminal part of the stroma, light brown to grey.  Perithecia pseudo-immersed, subglobose to broadly ellipsoidal, covering middle part of stroma, 200-250 × 120-200 µm.
Perithecia pseudo-immersed, subglobose to broadly ellipsoidal, covering middle part of stroma, 200-250 × 120-200 µm.  Asci 8-spored, filiform, 62.5-125 × 4-5 µm. Ascospores whole, filiform, 46-90 × 2-3 µm. Asexual morph Hirsutella, phialides arising singly or laterally from the hyphae along the terminal part of the stroma, 8-12 × 3-4 µm. Conidia, hyaline, oval, 5-7 × 2-3 µm.
Asci 8-spored, filiform, 62.5-125 × 4-5 µm. Ascospores whole, filiform, 46-90 × 2-3 µm. Asexual morph Hirsutella, phialides arising singly or laterally from the hyphae along the terminal part of the stroma, 8-12 × 3-4 µm. Conidia, hyaline, oval, 5-7 × 2-3 µm.
Culture characteristics:
Colonies on PDA attaining a diam of 25.5 mm within 20 d at 25 °C, cream to grey. Conidiogenous cells swollen towards the base, hyaline, smooth, tapering gradually towards the apex, which often forms a thin neck, monophialidic or polyphialidic, 15–28 × 3–5 µm. Conidia arising from phialides at the apex of each neck, globose to oval, one-celled, 4–6 × 2.5–4 µm, embedded in a mucous sheath.
Colonies on PDA attaining a diam of 25.5 mm within 20 d at 25 °C, cream to grey. Conidiogenous cells swollen towards the base, hyaline, smooth, tapering gradually towards the apex, which often forms a thin neck, monophialidic or polyphialidic, 15–28 × 3–5 µm. Conidia arising from phialides at the apex of each neck, globose to oval, one-celled, 4–6 × 2.5–4 µm, embedded in a mucous sheath.
Reference:
Tasanathai K, Noisripoom W, Chaitika T, et al. (2019). Phylogenetic and morphological classification of Ophiocordyceps species on termites from Thailand. MycoKeys 56: 101–129.
DOI: https://doi.org/10.3897/mycokeys.56.37636Species |
Strain |
Compound |
Pubchem CID |
Biological activity |
Reference |
|---|
|
Strain |
ITS | LSU | RPB1 | RPB2 | TEF1 |
|---|---|---|---|---|---|
| BCC 1764 | MH754730 | MH753684 | MK214114 | MK214098 | MK284271 |
| BCC 48071 | MH754728 | MH753682 | MK214112 | MK284269 | |
| BCC 48072 | MH754729 | MH753683 | MK214113 | MK284270 |